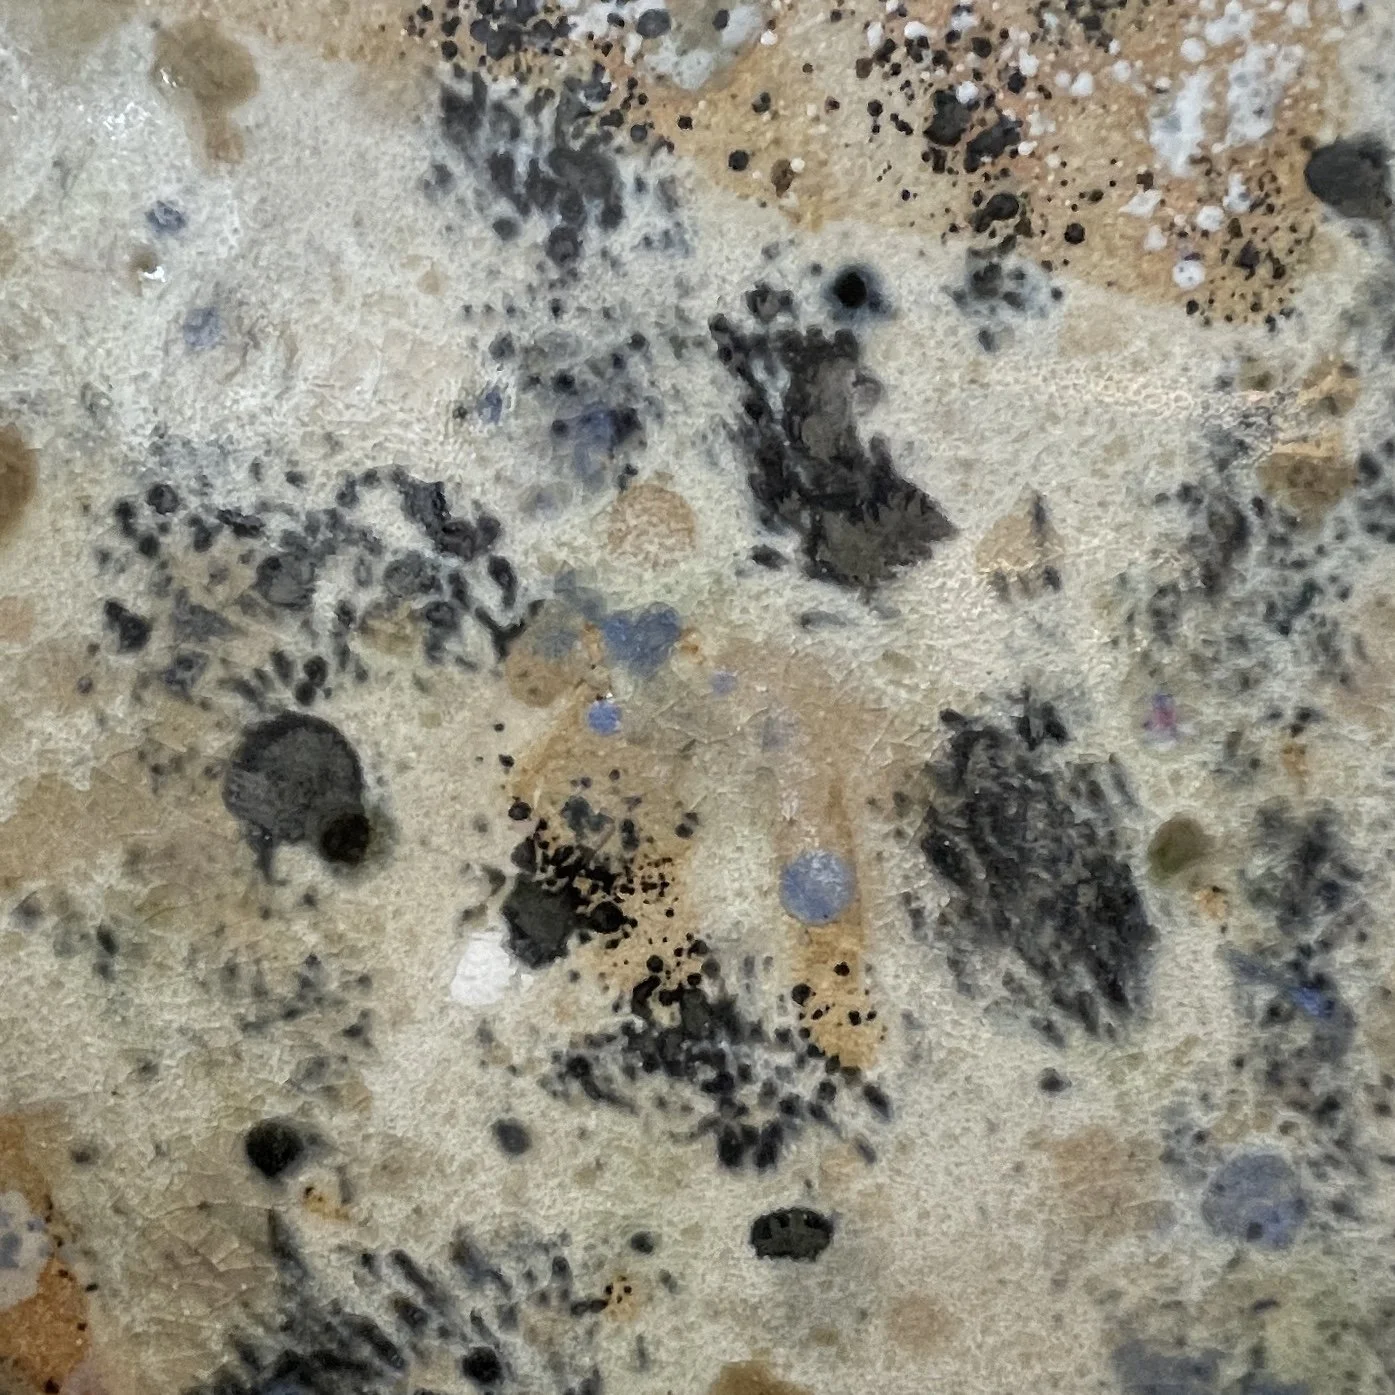
IMG_7855.jpeg

1. Puzzle
STUDIO SPACE
PROJECT DISCOURSE
“Noun: puzzle; a person or thing that is difficult to understand or explain; an enigma.”
ADDITIONS
Intimate, fragments, snapshots, scars, exposed, vulnerable, specific, fracture, fissure, tiles, penetrable, tension.
EXISTING CERAMIC STUDIES
NEW CERAMIC STUDIES
Material: Keanes terracotta earthenware clay with high iron stoneware &/ porcelain slip.
Process: Slab rolled clay tiles, slip applied using dip, scrap, brush and sprinkled methods.
Firing Temperature: Bisque 1000*C
VISUAL REFERENCES
Texture, Tapestry, Patchwork, Tiles, Binds.
Zoom, Snapshot, Allover, Depth, Layers.
Threads, Connections, Porosity, Exposed.
Tile, Fractured, Fissure, Mosaic, Softgeo.
RESEARCH
GALLERY VISIT
Location: MCA
Exhibition: Permanent Collection
THE WRAP
A week of setting up and then standing back to reflect on my ceramic exploration to date. The beginnings of research, and testing whilst processing information and clay!